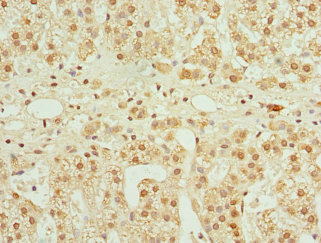

CFDP1 Antibody
-
中文名稱:CFDP1兔多克隆抗體
-
貨號:CSB-PA005272DSR1HU
-
規格:¥440
-
圖片:
-
其他:
產品詳情
-
產品名稱:Rabbit anti-Homo sapiens (Human) CFDP1 Polyclonal antibody
-
Uniprot No.:
-
基因名:CFDP1
-
別名:BCNT antibody; Bucentaur antibody; CENP-29 antibody; CFDP1 antibody; CFDP1_HUMAN antibody; CP27 antibody; Craniofacial development protein 1 antibody; p97 antibody; Phosphoprotein (Bucentaur) antibody; SWC5 antibody; Yeti antibody
-
宿主:Rabbit
-
反應種屬:Human
-
免疫原:Recombinant Human Craniofacial development protein 1 protein (1-299AA)
-
免疫原種屬:Homo sapiens (Human)
-
標記方式:Non-conjugated
-
克隆類型:Polyclonal
-
抗體亞型:IgG
-
純化方式:Antigen Affinity Purified
-
濃度:It differs from different batches. Please contact us to confirm it.
-
保存緩沖液:PBS with 0.02% sodium azide, 50% glycerol, pH7.3.
-
產品提供形式:Liquid
-
應用范圍:ELISA, IHC
-
推薦稀釋比:
Application Recommended Dilution IHC 1:20-1:200 -
Protocols:
-
儲存條件:Upon receipt, store at -20°C or -80°C. Avoid repeated freeze.
-
貨期:Basically, we can dispatch the products out in 1-3 working days after receiving your orders. Delivery time maybe differs from different purchasing way or location, please kindly consult your local distributors for specific delivery time.
-
用途:For Research Use Only. Not for use in diagnostic or therapeutic procedures.
相關產品
靶點詳情
-
功能:May play a role during embryogenesis.
-
基因功能參考文獻:
- Our findings provide new insight into the chromatin functions and mechanisms of the CFDP1 protein and contribute to our understanding of the link between epigenetic regulation and the onset of human complex developmental disorders. PMID: 28367969
- Overall, these findings highlight unanticipated evidences suggesting that homodimerization mediated by the BCNT domain is integral to the chromatin functions of BCNT proteins. PMID: 27151176
- Bcnt/Cfdp1 is acetylated in vitro by CREB-binding protein (CBP) and four lysine residues including Lys(268) in BCNT-C are also acetylated in vivo, revealing a protein regulated at multiple levels. PMID: 26182435
- This study identified rs4888378 in the BCAR1-CFDP1-TMEM170A locus as a novel genetic determinant of carotid intima-media thickness and coronary artery disease risk. PMID: 23152477
- includes the region derived from a long interspersed nucleotide PMID: 11831036
顯示更多
收起更多
-
亞細胞定位:Chromosome, centromere, kinetochore.
-
組織特異性:Ubiquitous.
-
數據庫鏈接:
Most popular with customers
-
-
YWHAB Recombinant Monoclonal Antibody
Applications: ELISA, WB, IHC, IF, FC
Species Reactivity: Human, Mouse, Rat
-
Phospho-YAP1 (S127) Recombinant Monoclonal Antibody
Applications: ELISA, WB, IHC
Species Reactivity: Human
-
-
-
-
-